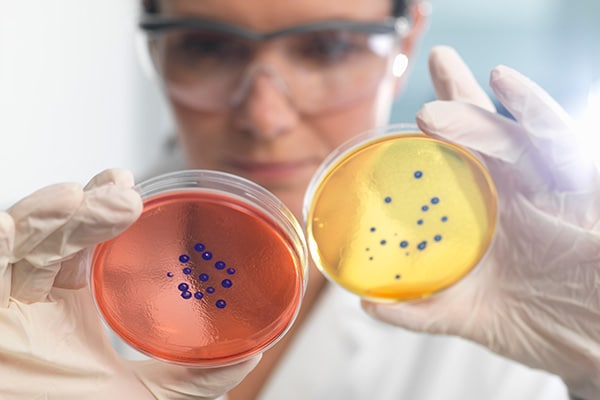
Cell Cultivation

Shimadzu strives to create lifecare innovation by developing technologies for supporting research of regenerative medicine using iPS cells, and drug discovery, and food science.
Drug Discovery

NARO Shimadzu Kyoto Laboratory for Food Innovation
- The National Agriculture and Food Research Organization (NARO) and Shimadzu established the NARO Shimadzu Kyoto Laboratory for Food Innovation within Shimadzu's Healthcare R&D Center in 2019.
- The research activities at the laboratory aim to generate scientific evidence for functionally beneficial components in foods, expected to offer a variety of benefits.
Osaka University - Shimadzu Analytical Innovation Research Laboratories
- 'Shimadzu Analytical Innovation Research Laboratories' was established on the Suita campus of Osaka University.
- We aim to actively promote various kinds of collaborative research in order to tackle the issue of extending healthy and active lifespan, focused on the use of omics with metabolomics at its core. We also hope to up the pace of innovation to provide direct solutions to these types of societal problems.
Shimadzu × Tohoku University Supersulfides Life Science Co-Creation Research Center
- Shimadzu and Tohoku University established the Shimadzu × Tohoku University Supersulfides Life Science Co-Creation Research Center in 2024.
- By identifying the properties of supersulfides involved in the aging mechanism of biological organisms, the collaboration is intended to contribute toward establishing diagnostic and treatment methods for a variety of diseases, and developing foods with functional benefits that help improve health.
Related Contents
Related Literature (Shimadzu Review)
- [SHIMADZU] Shimadzu Review Vol. 77 [3・4] Shimadzu Corporation Collaboration with National Agriculture and Food Research Organization (NARO) "Promoting Innovation and Contributing to Society through Food"
- [SHIMADZU] Shimadzu Review Vol. 77 [1・2] (2020) Life Science
- [SHIMADZU] Shimadzu Review Vol. 77 [1・2] Development of a Method of Evaluating the Undifferentiated State of Pluripotent Stem Cells by Multicomponent Analysis of Culture Supernatant
- [SHIMADZU] Shimadzu Review Vol. 75 [3・4] Development of Hydrogels Based on the Amphiphilic Copolymers Poly (Sarcosine) and Poly (L-Lactic Acid)
- [SHIMADZU] Shimadzu Review Vol. 75 [3・4] Development of Novel Tandem Mass Spectrometer (HAD-MS/MS) Using Gas-Phase Radicals
- [SHIMADZU] Shimadzu Review Vol. 75 [3・4] Development of Flow Field Flow Fractionation Device Suitable for Size Characterization of Biological Samples